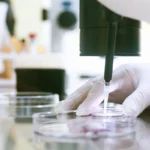

お知らせ 一覧
- Home
- お知らせ 一覧
2026年05月15日医療関係者・学生の方へ
【参加者募集】2026年度 看護師特定行為研修 オープンキャンパス・説明会

2027年度11期生募集に向けて、オープンキャンパスと説明会を開催します。 日程 オープンキャンパ …
2026年05月11日おくすりについて
2026年度第1回横浜市鶴見地域化学療法薬薬連携カンファレンスのお知らせ

2026年度第1回横浜市鶴見地域化学療法薬薬連携カンファレンス 日付:2026年6月23日(火)18 …
2026年04月30日メディア情報
【プレスリリース】「ナースコールが減った」 低侵襲手術が変える医療現場 済生会横浜市東部病院 「ダビンチ」によるロボット支援手術 年間 643 件到達

▲PDFはこちらまたは上記画像をクリックしてご覧ください
2026年04月30日ニュース
脳神経内科の伊達悠岳医師が「寺岡賞」を受賞しました

脳神経内科の伊達悠岳医師が、認知症に関する優れた臨床研究を顕彰する「2025年度寺岡賞」(公益財団法 …
2026年04月22日メディア情報
【メディア情報】谷口英喜医師の新著『いのちを守る飲水学 からだがよろこぶ水分補給のトリセツ』(評言社)が発刊されました

谷口英喜・患者支援センター長の新著『いのちを守る飲水学 からだがよろこぶ水分補給のトリセツ』が評言社 …
2026年04月20日メディア情報
【メディア情報】当院の専攻医へのインタビューが医学生・研修医向けサイト「HOKUTO」に掲載されました

当院の循環器内科専攻医の島津慶一朗医師へのインタビュー記事が医学生・研修医向けサイト「HOKUTO」 …
2026年04月17日ニュース
ご予約の変更・取り消しについてのお願い

当院では、患者さんお一人おひとりの診療計画に基づき、医師が予約日を決定しております。そのため、ご予約 …
2026年03月31日ニュース
広報誌『とーぶたいむ vol.46 春号』発刊

今号のコンテンツーーー 東部の良い時間をつくるものモノ。 TIME16 内田 力 事務部副部長 特集 …
2026年03月26日ニュース
リプロダクション外来より「ゴールデンウイークの休診について」
2026年5月2日(土)~5月6日(水)は、リプロダクションの診療を休診とさせていただきます。ご受診 …
2026年03月26日メディア情報
【メディア情報】当院の臨床研修プログラムについて医学生・研修医向けサイト「HOKUTO」に掲載されました

当院の臨床研修プログラムに関するインタビューが医学生・研修医向けサイト「HOKUTO」に掲載されまし …
